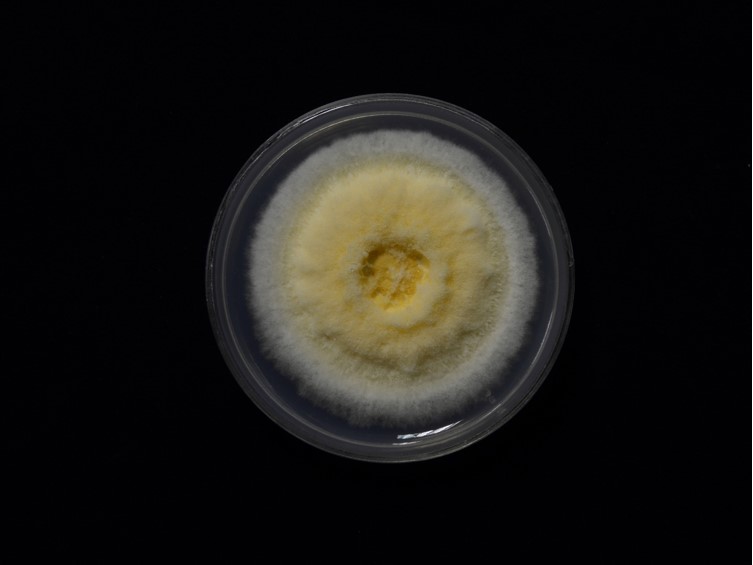

Holotype:
THAILAND, Chiang Mai Province, Ban Huai Baba community forest, 2 Nov. 2014, A. Khonsanit, D. Thanakitpipattana, K. Tasanathai, P. Srikitikulchai, W. Noisripoom, S. Wongkanoun, holotype BBH 40436, ex-type living culture BCC 75812.
Habitat:
Buried in the soil.
Host:
Coleoptera larva.
Description:
 Stromata arising from the posterior part of Coleoptera larva, approximately 2 cm buried in the soil, protruding from the forest floor with two stromata, claviform to cylindrical with rounded apices, simple, solitary, ellipsoid, 13-38 mm long, 2.5 mm wide. Stipe cylindrical, pale yellow to yolk yellow. Fertile head showing on the upper part of the stromata, rounded, ellipsoid, light yellow to yellow, 5-7 × 2.5 mm.
Stromata arising from the posterior part of Coleoptera larva, approximately 2 cm buried in the soil, protruding from the forest floor with two stromata, claviform to cylindrical with rounded apices, simple, solitary, ellipsoid, 13-38 mm long, 2.5 mm wide. Stipe cylindrical, pale yellow to yolk yellow. Fertile head showing on the upper part of the stromata, rounded, ellipsoid, light yellow to yellow, 5-7 × 2.5 mm.  Perithecia semi-immersed and crowded at the apex of the stromata, ovoid, 420-620 × 200-330 μm.
Perithecia semi-immersed and crowded at the apex of the stromata, ovoid, 420-620 × 200-330 μm.  Asci hyaline, cylindrical, capitate, 275-425 × 4-6 μm. Asci-caps hyaline, rounded, 2-3 × 4-5 μm.
Asci hyaline, cylindrical, capitate, 275-425 × 4-6 μm. Asci-caps hyaline, rounded, 2-3 × 4-5 μm.  Ascospores hyaline, filiform, multi-septate and breaks down into 32 part-spores 270-370 × 1-1.5 μm. Part-spores hyaline, cylindrical, 5.5-20 × 1-1.5 μm. Vegetative hyphae hyaline, septate, branched, smooth-walled, occasionally knotted wall. Phialide hyaline, solitary, smooth walled, occasionally knotted wall, base subspherical to lageniform, obpyriform, ampulliform, 3-10 × 1-3.5 μm.
Ascospores hyaline, filiform, multi-septate and breaks down into 32 part-spores 270-370 × 1-1.5 μm. Part-spores hyaline, cylindrical, 5.5-20 × 1-1.5 μm. Vegetative hyphae hyaline, septate, branched, smooth-walled, occasionally knotted wall. Phialide hyaline, solitary, smooth walled, occasionally knotted wall, base subspherical to lageniform, obpyriform, ampulliform, 3-10 × 1-3.5 μm.  Conidia hyaline, cylindrical with rounded apices or oblong, aseptate, smooth-walled, 4-9 × 1-2 μm.
Conidia hyaline, cylindrical with rounded apices or oblong, aseptate, smooth-walled, 4-9 × 1-2 μm.
Culture characteristics:
Colony on PDA dense especially in the middle and lateral clusters, convex to the agar surface floccose, cottony, 5 mm thick, white, greenish white, 40–42 mm diam in 20 d.
Colony on PDA dense especially in the middle and lateral clusters, convex to the agar surface floccose, cottony, 5 mm thick, white, greenish white, 40–42 mm diam in 20 d.
Reference:
Khonsanit A, Luangsa-ard JJ, Thanakitpipattana D, et al. (2020). Cryptic diversity of the genus Beauveria with a new species from Thailand. Mycological Progress 19: 291–315.
DOI: https://doi.org/10.1007/s11557-020-01557-9Species |
Strain |
Compound |
Pubchem CID |
Biological activity |
Reference |
|---|
|
Strain |
Bloc | ITS | RPB1 | TEF1 |
|---|---|---|---|---|
| BCC 75812 | MN401542 | MN401672 | MN401597 | MN401500 |
| BCC 75813 | MN401543 | MN401673 | MN401598 | MN401501 |